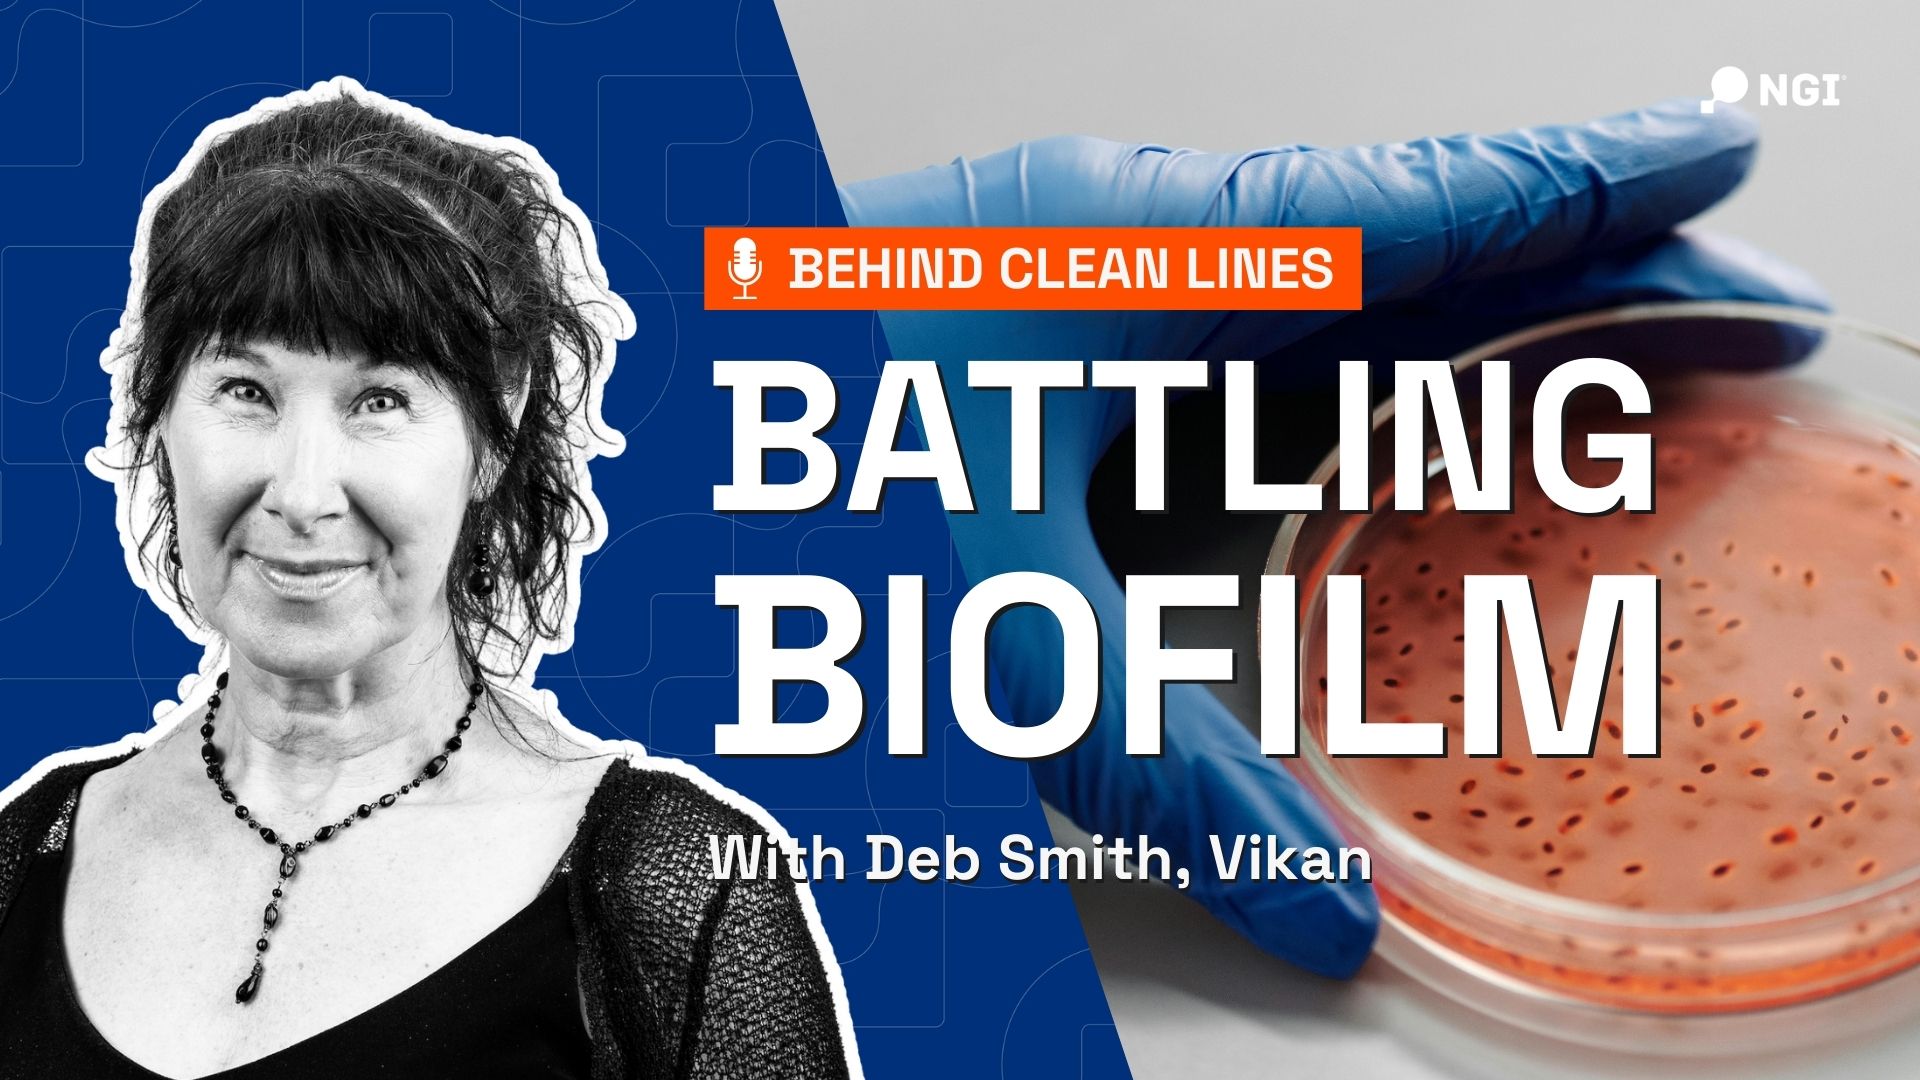
Behind Clean Lines: Folge 17

Archivierte Nachrichten!
Willkommen in unserem Bereich „Archivierte Nachrichten“!
Diese Artikel sind zwar nicht mehr ganz aktuell, aber sie sind nach wie vor eine wertvolle Quelle für Einblicke, Innovationen und Branchenentwicklungen.
Entdecken Sie frühere Artikel, Produkteinführungen und Diskussionen, die den Lebensmittelverarbeitungssektor geprägt haben. Wissen veraltet nie – tauchen Sie ein und entdecken Sie wichtige Momente neu!